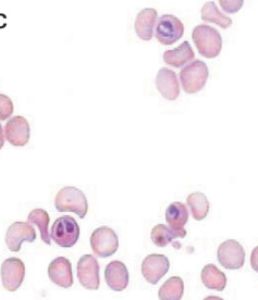

Piroplasmosis bovina
Parasitología veterinaria
La Piroplamosis bovina, tristeza, fiebre de las garrapatas o fiebre de texas es una enfermedad causada por Babesia bigemina.
Enfermedad - Sinonimia:
Enfermedad - Sinonimia:
Piroplamosis bovina, tristeza, fiebre de las garrapatas, fiebre de texas.
Agente causal:
Babesia bigemina. Endoparasito protozoario.
Periodo de incubación:
Esta enfermedad tiene un período de incubación que oscila entre los siete y los quince días.
Hospedador intermediario:
El hospedador intermediario de la babesia es la garrapata Boopphilus microplus.
Sintomatología:
La piroplasmosis se puede presentar de dos maneras diferentes:
- Forma benigna: Presenta un ligero aumento en la temperatura, disminución del apetito y aumento del ritmo respiratorio. Es una enfermedad de curso leve y el animal por lo general se repone sin mayor esfuerzo.
- Forma hemoglobinurica: Alcanza temperaturas hasta de 42ºC, disminución del apetito, el animal se aleja del rebaño y aumenta en consumo total de agua, luego se presenta la hemoglobinuria y en la mayoría de los casos los animales se postran y mueren.
Patología:
La Babesia bigemina produce un daño celular relacionado con la hemolisis que es directamente proporcional a la parasitemia causando anorexia y lesiones inflamatorias secundarias en varios órganos, principalmente hígado y riñones. El parásito generalmente se ubica en eritrocitos jóvenes.
Inmunología:
La resistencia a una reinfestación depende de la presencia del parásito en el organismo, por lo general se mantiene por dos o tres años.
Diagnóstico:
Determinación del parásito por hematología.
Tratamiento:
El tratamiento depende de productos químicos con diminaceno o imidocarb como principio activo.


